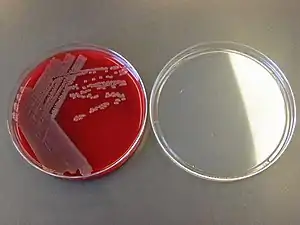

سویه
سویه (به انگلیسی: strain) در زیستشناسی به یاختههایی که در کشت خالص، از یک یاخته بهدست آمدهاند میگویند. در تعریف ژنوتیپی، سویه به سلولهایی گفته میشود که با سویههای دیگر کمتر از ۱۲٪ تفاوت ژنتیکی داشته باشد. سویهها را با شماره، حروف یا نامگذاری که بهدنبال نام یک گونهٔ زیستی میآید مشخص میکنند.
در باکتریها، به مجموعهای از سویهها که در بسیاری از صفات با هم مشترک باشند گونه گفته میشود. هرگاه دو سویهٔ باکتری در ۳۰ درصد از دیانایشان تفاوت نشان دهند، میتوان آنها را گونههای جداگانهای در نظر گرفت.[1] البته این یک عدد قراردادی و کاربردی است.
هر سویه ای که دارای مشخصات تعیین شده از قبیل محل جداسازی، فرد کاشف، تاریخ کشف، خواص ظاهری و ژنتیکی و موارد دیگر باشد اصولاً یک سویه اصطلاحاً شناسنامه دار یا به عبارت دیگر یک سویه استاندارد میباشد.
به دلیل اینکه هر سویه استاندارد برای اولین بار در یک کشور مشخص شناسایی شده و به ثبت رسیدهاست و گاهی آن کشور و منطقه خاستگاه اصلی سویه میباشد لذا سویههای استاندارد را میتوان بخشی از ذخایر ژنتیکی یک کشور محسوب نمود.
کشورهای مختلف سویههای استاندارد را در کلکسیونها و بانکهای اختصاصی نگهداری کرده و متناسب با نام کشور و بانک خود به سویهها شماره یا کد اختصاص میدهند؛ بنابراین تمام سویههای استاندارد دارای چندین کد یا شماره هستند که توسط بانکهای زیستی کشورهای مختلف به آنها تعلق گرفتهاست و تمامی کدها از کلکسیونی به کلکسیون دیگر قابل انطباق میباشد.
کشور آمریکا بزرگترین و معتبرترین بانک زیستی دنیا را در اختیار دارد(www.atcc.org) و تمامی سویههای آن با کد گذاری ATCC شناخته میشوند یا سویههای استاندارد کشور آلمان (www.dsmz.de) با کد گذاری DSM شناخته میشوند (برای هر سویه پس از ATCC یا DSM یک عدد اختصاصی قرار دارد)
چون سویههای استاندارد دارای خصوصیات شناخته شده میباشند لذا از آنها میتوان به عنوان یک ابزار جهت کنترل کیفی سویههای دیگر، محیطهای کشت و آنتیبیوتیکها استفاده نمود و از این جهت دارای اهمیت ویژهای میباشند.
منابع
- شهامت، منوچهر، ملکزاده، فریدون، میکروبیولوژی عمومی، تهران: نتشارات شهرآب، پاییز ۱۳۶۹. ص۳۴۴.
- و در مورد گونه این اختلاف بین ۱۲ تا ۲۰٪ است و سلولهایی که بیش از ۲۰٪ تفاوت ژنتیکی داشته باشند در دو سرده متفاوت قرار میگیرند.